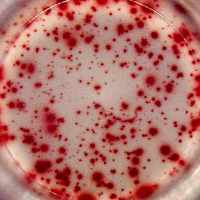

Monkey interferon-gamma ELISPOT:
IFN-gamma specific spots produced by 2.5x10E3 rhesus macaque PBMC.
Stimulation: PMA/ionomycin.
IFN-gamma specific spots produced by 2.5x10E3 rhesus macaque PBMC.
Stimulation: PMA/ionomycin.
Catalogue Number
CT121-PR2
Description
Monkey IFN-γ T cell ELISPOT kit - 2-plate
Price
€ 465.00
staining
Enzymatic
Characteristics
PVDF
Contents
- monoclonal coating antibodies
- biotinylated monoclonal detection antibodies
- Streptavidin-Horseradish Peroxidase
- AEC coloring system
- Blocking stock solution
- Dilution buffer R
- Tween-20
- PVDF ELISPOT plates with lids and cover slips
- detailed manual
specificity
- rhesus macaque
- Cynomolgus monkey
- Pig-tailed macaque
- Baboon
- african green monkey
References list
- A Next-Generation Adenoviral Vaccine Elicits Mucosal and Systemic Immunogenicity and Reduces Viral Shedding after SARS-CoV-2 Challenge in Nonhuman Primates.
- Vaccine-induced neutralizing antibody responses to seasonal influenza virus H1N1 strains are not enhanced during subsequent pandemic H1N1 infection.
- Poxvirus MVA Expressing SARS-CoV-2 S Protein Induces Robust Immunity and Protects Rhesus Macaques From SARS-CoV-2.
- Host Immune Responses after Suprachoroidal Delivery of AAV8 in Nonhuman Primate Eyes.
- Protective Immune Responses Elicited by Deglycosylated Live-Attenuated Simian Immunodeficiency Virus Vaccine Are Associated with IL-15 Effector Functions.
- SIV Infection Facilitates Mycobacterium tuberculosis Infection of Rhesus Macaques.
- T- and B-cell responses to multivalent prime-boost DNA and viral vectored vaccine combinations against hepatitis C virus in non-human primates.
- HIV-1 vaccines based on replication-competent Tiantan vaccinia protected Chinese rhesus macaques from simian HIV infection.
- Use of an Sm-p80-based therapeutic vaccine to kill established adult schistosome parasites in chronically infected baboons.
- Vaccine-induced protection of rhesus macaques against plasma viremia after intradermal infection with a European lineage 1 strain of West Nile virus.
- No difference in Gag and Env immune-response profiles between vaccinated and non-vaccinated rhesus macaques that control immunodeficiency virus replication.